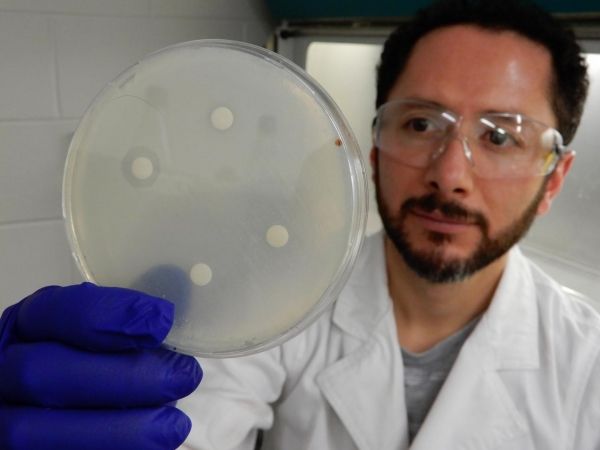

A chemical compound found in common herbicides could help fight hospital-acquired human fungal pathogenic infections, which claim an estimated two million lives per year.
A team of international researchers led by The University of Queensland has discovered that the chemical chlorimuron ethyl also targets a range of fungal infections that are potentially fatal to humans, particularly people undergoing treatments which place the immune system under stress.
Dr Luke Guddat, from UQ’s School of Chemistry and Molecular Biosciences, said the finding was very timely, given the growth in drug-resistant infections.
“There are more drug-resistant fungal diseases than ever – posing a major threat to global human health – and new drugs are urgently required to combat these diseases,” he said.
Read more at University of Queensland
Image: UQ's Dr Mario D. Garcia conducting one of the many experiments involved in the research. (Credit: The University of Queensland)